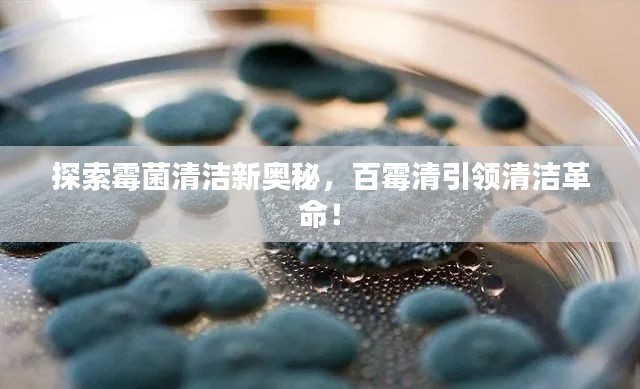

在这个日新月异的科技时代,我们每天都在接触各种各样的信息。"百霉清"作为一个关键词,逐渐引起了人们的关注。"百霉清"究竟是何物?它又有哪些独特的功效和应用场景呢?让我们一起来百度一下,揭开百霉清的神秘面纱。
百霉清的基本概念
百霉清是一种高效、低毒的霉菌清洁剂,主要用于清除各种霉菌污染,它具有强大的杀菌能力和良好的环保性能,广泛应用于家庭、工业、农业等领域,百霉清的主要成分能够破坏霉菌的细胞结构,从而彻底杀灭霉菌,并防止其再次生长繁殖。
百霉清的应用场景
1、家庭清洁:在家庭环境中,百霉清可以有效清除卫生间、厨房、地下室等潮湿区域的霉菌污染,保持家居环境的健康。
2、工业应用:在工业领域,百霉清可用于清除设备、管道、仓库等地方的霉菌,保障生产过程的顺利进行。
3、农业生产:在农业上,百霉清可用于防治农作物病害,提高农作物的产量和品质。
百霉清的优势特点
1、杀菌彻底:百霉清的主要成分能够深入霉菌细胞内部,破坏其结构,从而达到彻底杀灭霉菌的效果。
2、环保安全:百霉清采用环保原料制成,无毒无害,对人体和环境安全。
3、适用范围广:百霉清可广泛应用于家庭、工业、农业等多个领域,具有普遍的应用价值。
百霉清的使用方法
使用百霉清时,首先需将清洁表面清洗干净,然后按照一定比例将百霉清稀释后喷洒或涂抹在需要清洁的表面,待其作用一段时间后,用清水冲洗干净即可。
百霉清的注意事项
1、在使用百霉清时,需佩戴好口罩和手套,避免直接接触皮肤和呼吸道。
2、请将百霉清存放在阴凉、干燥处,避免阳光直射和高温。
3、如不慎溅入眼睛,请立即用清水冲洗,并寻求医生帮助。
通过百度了解百霉清,我们发现它是一种高效、环保的霉菌清洁剂,具有广泛的应用前景,无论是在家庭、工业还是农业领域,百霉清都能发挥其强大的杀菌作用,为我们创造一个更健康、更美好的生活环境,希望这篇文章能帮助你更好地了解百霉清,并在需要的时候正确选择和使用它。
转载请注明来自成都华通顺物流有限公司,本文标题:《探索霉菌清洁新奥秘,百霉清引领清洁革命!》

蜀ICP备2022005971号-1
还没有评论,来说两句吧...